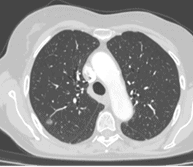

Chirurgie thoracique robot-assistée
Nous pratiquons la chirurgie thoracique robot-assistée depuis 2018 au CH de la Côte Basque
(1er centre d’Aquitaine et 2ème CH de France)
Centre robotique sélectionné pour l’audit qualité Epithor
Le robot chirurgical


De quoi s’agit-il ?
Ce n’est pas un robot à proprement parlé:
- Aucune tâche automatisée
- Aucune intelligence artificielle
C’est un outil :
- un bras articulé manipulé par un chirurgien
Les atouts majeurs:
- Une vision augmentée en 3 dimensions plus précise
- Des instruments microchirurgicaux articulés
- Une ergonomie adaptée à chaque chirurgien
A quoi ça sert ?
- Permet de faire en abord mini invasif pour des interventions complexes
- évite une grande ouverture
Les opérations que nous pratiquons au robot en chirurgie thoracique sont principalement :
- Plasties du diaphragme
- Lobectomies pulmonaires
- Segmentectomies pulmonaires
- Thymectomies
- Tumeurs du médiastin


pour manipuler les bras du robot chirurgical

en 3 dimensions
Endovasculaire

De quoi s’agit-il ?
La chirurgie endovasculaire permet d’opérer les pathologies des veines et des artères via l’intérieur des vaisseaux et évite leur ouverture directe.
Les interventions utilisent le plus souvent l’assistance des rayons X, avec des appareils d’imagerie installés dans la salle d’opération.
A quoi ça sert ?
Les opérations que nous pratiquons en endovasculaire sont principalement:
- Pour les veines:
- Utilisation de la radiofréquence (ultrasons) pour traiter les varices
- Pour les artères:
- Anévrysmes et pathologies occlusives de l’aorte et des artères des membres inférieurs
- Endoprothèses aortiques abdominales y compris en urgence pour les anévrysmes
Collaboration avec le CHU de Bordeaux pour les endoprothèses fenêtrés (FEVAR) - Utilisation par le service des dispositifs disponibles les plus modernes pour les thromboses des artères
- thrombectomie percutanée (Indigo Penumbra et Rotarex): permettant de retirer des caillots sanguins dans les vaisseaux,
- athérectomie intravasculaire (Jetstream, Boston Scientific): permettant d’enlever par l’intérieur les plaques d’athérome qui bouchent les artères,
- lithotripsie intravasculaire (ShockWave): permettant la destruction de la plaque calcifiée qui obstrue l’artère.
Nous utilisons par ailleurs des dernières techniques de surveillance pendant l’opération de la fluidité du sang:
ACT pour contrôler le dosage des anticoagulants pendant l’opération (Monitoring intra opératoire de l’héparinothérapie)
Mini-sonde endobronchique
De quoi s’agit-il ?
Cette technique nécessite un fibroscope bronchique, c’est-à-dire une caméra miniaturisée permettant d’explorer le poumon et les bronches de l’intérieur, par les voies naturelles.
La minisonde est une sonde de 2 mm qui s’insère dans le fibroscope permettant compte tenu de sa petite taille d’ aller plus loin dans les bronches de petit calibre. Cette minisonde est elle-même équipée d’une sonde d’échographie, miniaturisée à l’extrême, permettant d’examiner le poumon de l’intérieur.
A quoi ça sert ?
Ainsi des cancers à des stades plus précoces qu’auparavant peuvent être repérés et opérés.

Reconstructions 3D

De quoi s’agit-il ?
Nous reconstruisons l’anatomie du patient en 3 dimensions grâce à un scanner thoracique (en utilisant le logiciel Synapse 3D) avant l’opération afin de la préparer car chaque patient est unique et chaque anatomie est différente.
A quoi ça sert ?
Les reconstructions 3D permettent au chirurgien de :
- diminuer la durée de l’intervention chirurgicale grâce à un gain de temps de dissection
- planifier le déroulé de l’intervention chirurgicale, c’est-à-dire , prévoir les étapes de dissection de l’organe
- réaliser des interventions plus complexes qu’auparavant grâce à une meilleure précision de la connaissance de l’anatomie du patient qui est soigné
- diminuer le risque d’erreur anatomique pendant l’opération quand les patients ont une anatomie inhabituelle
- diminuer le risque d’accident hémorragique lors de l’intervention
- améliorer les marges de résection de sécurité d’une tumeur en augmentant ainsi la qualité oncologique du geste


